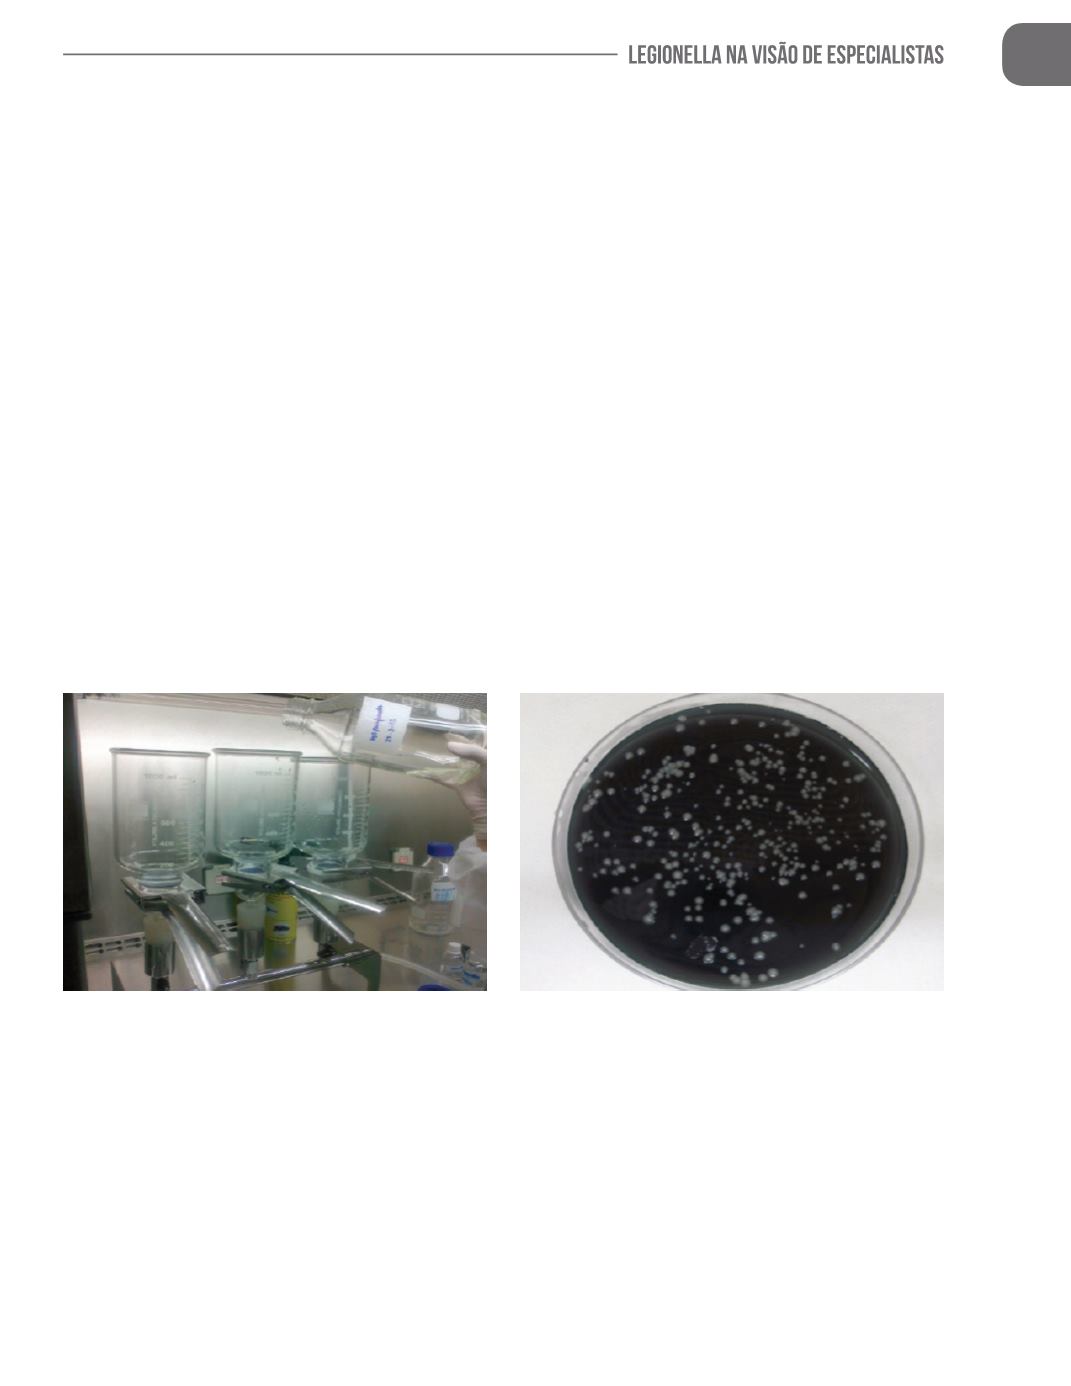

199
amostra, pode ocorrer à perda de
Legionella
viável durante o transporte,
e desta forma ter um resultado “falso negativo”, dando certo conforto e
tranquilidade “irreal”.
O efeito de lise de protozoários também pode ocorrer no momento
do processamento da amostra; porque nométodo ISO 11731-2, o ensaio
é feito por filtração, como ilustrado na figura 01, onde se utiliza um filtro
de membrana com poros microscópicos e uma bomba de vácuo para a
sucçãoda água; issoperturba fortemente a amostra, oque pode ocasionar
o rompimentodeamebas, e liberaraltaconcentraçãode
Legionella
naágua,
acarretando um resultado falso-posivo. Na figura 02 segue ilustração de
positivopara
Legionellapneumophila.
Figura01
–Procedimentodefiltraçãoda técnica
ISO1173102
Figura02
–Presençadabactéria
Legionella
pneumophila, isoladapelométodo ISO11731-2.